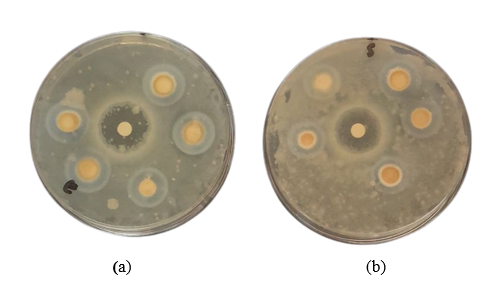

Trends Sci. 2026; 23(1): 11055
Evaluation of Calcium Oxide (CaO) from Oyster Shell Waste: A Sustainable Heat-Generating and Antimicrobial Agent
I
Gusti Ayu Budiadnyani
1,
![]() ,
Pinky Natalia Samanta
1,
,
Pinky Natalia Samanta
1,
![]() ,
,
Fenny
Crista Anastasia Panjaitan
1,
![]() ,
Anis Khairunnisa
1,
,
Anis Khairunnisa
1,
![]() and I Made Aditya Nugraha
2,
and I Made Aditya Nugraha
2,
![]()
1 Marine Product Processing Department, Polytechnic of Marine and Fisheries of Jembrana,
Jembrana, Bali 82218, Indonesia
2 Department of Fisheries Mechanization, Marine and Fisheries Polytechnic of Kupang, Kupang,
East Nusa Tenggara 85351, Indonesia
( * Corresponding author’s e-mail: [email protected])
Received: 24 June 2025 , Revised: 15 August 2025, Accepted: 22 August 2025, Published: 30 October 2025
Abstract
Oyster shell waste is a source of calcium carbonate (CaCO 3 ) that has the potential to be processed into calcium oxide (CaO) through a calcination process. CaO has various applications, including as a heat-generating agent and antimicrobial. However, proper calcination temperature optimization is needed to obtain CaO with optimal physical and chemical properties. This study aims to optimize CaO production from oyster shell waste and to produce its potential in exothermic and antimicrobial applications The method used involves a calcination process at temperatures of 750, 900, and 1000 °C. The CaO produced was characterized at 750, 900, and 1000 °C. CaO characterization was carried out using Scanning Electron Microscopy (SEM) for morphological analysis, X-Ray Diffraction (XRD) for crystallinity, Fourier Transform Independent Spectroscopy (FTIR) for functional groups, and thermogravimetry (TGA) for thermal stability. The pH test was carried out to determine the basicity, while the antibacterial test used the disc diffusion method against Escherichia coli and Staphylococcus aureus . The results showed that calcination at 1000 °C produced CaO with high purity and porous structure that increased the surface area. The pH stability in the range of 12.5 indicated strong basic properties. CaO produced at 1000 °C exhibited significant exothermic reaction when reacting with air, proving its potential as a heat generating agent (T = 100 °C at 12 min with ∆H = −64.9 kJ/mol). It is also revealed great inhibition against E. coli (1.32 mm) and S. aureus (1.36 mm). In conclusion, oyster shell waste-derived CaO is a highly promising sustainable solution for both heat generation and antimicrobial applications, which strongly supports a circular economy approach in biogenic waste management.
Keywords: Antimicrobial, Calcination, Calcium oxide, Exothermic, Oyster shell
Introduction
Oyster shell waste is one of the by-products of the fisheries industry and public consumption that is still not optimally utilized [1-3]. Most oyster farming currently takes place in Asia and accounts for about 95% of global production, resulting in significant shell waste [4]. These discarded shells, if unmanaged, accumulate in coastal areas, posing risks such as foul odor, habitat alteration, and leaching of calcium compounds into marine ecosystems. In fact, oyster shells have a high
calcium carbonate (CaCO₃) content, which can be converted through a calcination process into calcium oxide (CaO) [3,5]. CaO is known to have various benefits, including as an exothermic heat-generating agent and as a natural antimicrobial material [6-12] . Despite its potential, the application of CaO derived from oyster shells in exothermic and antimicrobial functions remains underexplored. This study aims to optimize its production and evaluate its broader utility in these applications.
Currently, many industries still rely on synthetic chemicals for exothermic heating and antimicrobial applications [9,13-15]. The use of these chemicals can have negative impacts on the environment and human health [16,18]. In addition, improper disposal of oyster shells waste contributes to environmental pollution, particularly in coastal areas. Addressing these issues, this study aims to contribute to the valorization of oyster shell waste as a potential step toward reducing environmental burden, while identifying sustainable alternatives that are both environmentally and economically viable [19-25].
The previous studies have demonstrated the utility of oyster shell-derived CaO in areas like carbon dioxide absorption and catalysis [3,18]. The antimicrobial activity was influenced by the alkaline effect caused by the hydration of CaO in calcined powder solution. The study of the application of CaO as an antibacterial from calcined oyster shell powder can maintain the shelf life of fresh shrimp for more than 12 days in cold conditions [23]. However, specific research into its potential as an exothermic heat source and antimicrobial agent is limited. Therefore, this study aims to fill this gap by characterizing the produced CaO and evaluating its effectiveness against microbial growth [25].
The novelty of this study is more emphasized on the utilization of CaO as a food heating agent and as a food preservative because it has antimicrobial activity [26-29]. In the food industry, exothermic heating can be utilized for ready-to-eat foods or certain processing processes, while its antimicrobial properties can help extend the shelf life of food. There has been no study using CaO from oyster shells for both exothermic and antimicrobial purposes simultaneously. Thus, this research offers significant contributions to both the food and health industries [30-36] .
This study aims to examine the oyster shell calcination process for producing calcium oxide, analyze its exothermic properties, and assess its effectiveness as a natural antimicrobial agent against certain microorganisms. Thus, this study is expected to contribute to the wider utilization of organic waste and offer more sustainable solutions for the industrial and health sectors. This temperature comparison is used to determine the optimal temperature in producing CaO with the best characteristics. These methods are expected to provide a deeper understanding of the characteristics and potential utilization of CaO from oyster shell waste in various applications. By comparing the calcination results at 3 different temperatures, this study aims to determine the optimal conditions in producing CaO with maximum exothermic properties and antimicrobial activity.
Materials and methods
This study was conducted through a series of analyses, including color analysis, Ca analysis, yield percentage analysis, pH measurement, FTIR analysis, SEM analysis, XRD, thermogravimetric analysis (TGA), and antimicrobial testing to characterize the calcined CaO and test its exothermic properties and antimicrobial activity. Calcination was performed at 3 distinct temperatures: 750, 900, and 1000 °C to determine the optimal temperature in producing CaO with the most desirable characteristics from oyster shell waste, specifically maximizing its exothermic properties and antimicrobial activity. This research will deepen our understanding of CaO’s potential uses.
Oyster shell waste processing for CaO production
Oyster shell waste, collected from seafood restaurants in Jembrana Regency ( Figure 1 ), Bali, Indonesia, was carefully prepared through a detailed process. Initially, the shells were scrubbed under running water to eliminate dirt and organic matter.

Figure 1 Map of sampling location.
After the initial washing stage, the shells were soaked in a 10 %w/v sodium hydroxide (NaOH) solution for 24 h. This soaking process was adapted from previous studies to effectively remove residual meat, fat, and other organic compounds adhered to the shell surface [21,27]. This crucial step aimed to eliminate any remaining meat, fat, or other organic compounds. Following the soaking process, the shells were thoroughly rinsed repeatedly with distilled water to ensure all traces of NaOH residue were completely removed. The final rinse water was checked to ensure a neutral pH, confirming the removal of residual NaOH. The clean shells were then drained and dried in the sun for 24 h until completely dry. The dried shells were stored in a clean and dry container to be further processed into shell powder.
For further processing, the shells were oven-dried at 105 °C for 2 h. After that, the completely dry shells were crushed manually using a mortar into small pieces. These shell pieces were then ground using a grinding machine (Fomac FGD-Z200, PT Fomac Internusa, Jakarta, Indonesia) to obtain a fine powder with a particle size of 100 mesh. This size was selected based on previous work showing improved calcination uniformity at fine particle sizes [2]. The resulting shell powder was stored in a closed container and placed in a desiccator to maintain stability and prevent absorption of moisture from the surrounding environment. Furthermore, the shell powder was subjected to a calcination process in a heating furnace for 5 h at 3 distinct temperatures: 750, 900, and 1000 °C. Overall, oyster shell waste processing for CaO production is depicted in Figure 2 .

Figure 2 Flowchart of oyster shell waste processing for CaO production.
After the calcination process was complete, the CaO powder produced gradually reached room temperature, then stored in an oven to prevent absorption of moisture from the air. The results of each CaO powder sample were calculated using Eq. (1) [37] . Where W2 is the final weight after the calcination process, and W1 is the initial weight of the shell powder before calcination.

Data analysis
To support this research, several analyses were performed, including color analysis, calcium (Ca) content analysis, yield percentage, pH measurement, FTIR spectroscopy, SEM analysis, XRD analysis, TGA analysis, and antimicrobial activity test. Detailed descriptions of each analysis are provided below.
Heat releasing analysis
CaO powder was weighed at 50 g and placed in a closed beaker glass. The CaO powder was then reacted with distilled water (1:2 v/v). The heat generated during the reaction and the duration of the reaction were recorded using digital thermometer stick (Taffware, Indonesia).
Color analysis
The color of the CaO powder samples was measured using a smartphone-based Colorimetric application under standardized lighting [36,37]. Smartphone with 48 MP rear wide camera (ƒ/1.78 aperture, 24 mm equivalent focal length), was used to capture images of the sample surface. Photos were taken from a fixed distance of 20 cm using a tripod to ensure stability and consistency. Illumination was provided by 1 daylight LED lamps (10 W, 6500 K), placed symmetrically at 45° angles. Color measurements were carried out in the CIE L* a* b* color space, which allows color characterization based on 3 parameters, namely brightness (L*), color shift towards red or green (a*), and color shift towards yellow or blue (b*). The total color difference is calculated using Eq. (2) [28] .

CaO analysis
Measurement of CaO levels was carried out to determine the efficiency of the calcination process at various temperatures and to ensure the calcium content in the calcined samples. These results are used to determine how the calcination temperature affects the amount of CaO obtained from oyster shells. The calcium content was quantified using Atomic Absorption Spectrophotometry (AAS, PerkinElmer AAnalyst 400, USA) at a 422.7 nm with an air-acetylene flame following established procedures for Ca determination in biogenic calcium-rich materials [38]. Approximately 0.2 g of sample shell powder was digested in 10 mL of concentratednitric acid (HNO 3 , Merck) and heated at 80 °C for 30 min to ensure complete dissolution. The solution was filtered and diluted to 50 mL with deionized water before AAS measurement. This analysis aimed to evaluate the efficiency of CaO formation at different calcination temperatures (750, 900, and 1000 °C) and determine the effect of temperature on Ca content.
pH measurement
The procedures pH analysis was carried out by dissolving the calcined CaO sample in water and measuring its basicity using a pH meter (Smart Sensor AS847, Dongguan Wanchuang Electronic Products Co., Ltd., China). These analysis were carried out by dissolving approximately 1 g of CaO powder sample in 10 mL phosphate buffer solution (pH 5.8 - 7.4) [17]. This measurement aims to evaluate the stability of the basic properties of the CaO produced at different temperatures and its potential in various applications, including as an antimicrobial agent.
FTIR Spectroscopy
Procedures of FTIR analyzed was measured using the Fourier infrared spectrophotometer over the range of 4000 to 400 cm −1 at a 2 cm −1 resolution and averaging 64 scans [38]. This analyzed was used to identify functional groups in the resulting CaO compound using FT-IR spectroscopy (IRPrestige 21, Shimadzu Corp., Kyoto, Japan). This analysis helps to confirm the presence of specific chemical bonds and changes in chemical structure due to calcination at various temperatures.
SEM analysis
Used to observe the morphology and surface structure of CaO particles produced at each calcination temperature using SEM (FEI Inspect S50, Bestscope, China). This technique allows observation of the size, shape, and distribution of the formed crystal particles, which can affect their exothermic properties and antimicrobial activity [39].
Antimicrobial activity test
The test was conducted using agar diffusion method or other methods to evaluate the effectiveness of CaO in inhibiting the growth of certain microorganisms. The test organisms used were E. coli (ATCC 25922) and S. aureus (ATCC 25923), representing Gram-negative and Gram-positive bacteria. Bacterial suspensions were prepared to a turbidity equivalent to 0.5 McFarland standard, and then evenly spread on Mueller-Hinton agar (MHA) plates. Wells with a diameter of 6 mm were created in the agar, and each was filled with 100 µL of CaO suspension (10 mg/mL) from samples calcined at different temperatures (750, 900, and 1000 °C). The plates were incubated at 37 °C for 24 h. After incubation, the diameter of the inhibition zones around the wells was measured to determine the antibacterial effect [40]. The antimicrobial activity was compared based on CaO samples from various calcination temperatures to determine the optimal temperature that produces the best antibacterial effect.
Statistical analysis
The data obtained in this study are presented in the form of figures, tables, and graphs. Statistical analysis was performed using One-Way ANOVA with SPSS 22.0 (SPSS Statistical Software, Inc., Chicago, IL, USA), followed by Duncan’s post hoc test, where different letters indicate significant differences ( p < 0.05) with a confidence level of 95%. The data are expressed as mean ± standard deviation.
Results and discussion
Appearance and color of oyster shells
The visual characteristics and color of oyster shells ( Crassostrea virginica ) that have undergone the calcination process at various temperatures can be seen in Figure 3 . Before calcination, oyster shells have a flat shape resembling coral with a hard and strong texture. The outside of the shell is brownish, while the inside is white. The structure and color of this shell are influenced by the habitat and environmental conditions where the shellfish live [38,41].
After being dried and ground into a 100-mesh flour, the color of the oyster shell powder changes to grayish white with a smooth texture. This color difference compared to other types of shellfish is caused by the mineral content and organic compounds contained in the shells before the calcination process [39].
At the calcination stage, oyster shell flour experiences a significant color change according to the increase in heating temperature. After being calcined at a higher temperature, the color changes to green and brownish gray. Based on the results of color measurements on green mussel shell ash calcined at different temperatures ( Table 1 and Figure 3 ).
This color change indicates the degradation of organic compounds and the transformation of minerals in oyster shells due to exposure to high temperatures. With increasing calcination temperature, the color of the shell ash tends to become brighter, which is related to the decomposition of carbonate and changes in the crystal structure of minerals in the shell [39,40].
At the calcination stage, oyster shell flour undergoes significant color changes along with increasing heating temperature. This color change reflects the transformation of chemical composition that occurs during the calcination process. The observation results show that at higher temperatures, oyster shell ash changes color to green and brownish gray. To further understand the effect of temperature on this color change, color measurements were taken on green oyster shell ash calcined at various temperatures. Table 1 presents the measurement results, highlighting the variations in color parameter values at each temperature. A more detailed visualization of the color changes is provided in Figure 3 .
Table 1 Color values of the calcined Shell powder at various temperatures.
|
Parameter |
Calcination temperature ( C) |
Value* |
|
L * |
750 900 1000 |
67.17 b 59.57 a 83.50 c |
|
a * |
750 900 1000 |
1.76 c 0.82 a 1.00 b |
|
b * |
750 900 1000 |
5.73 b 6.23 c 4.82 a |
|
|
750 900 1000 |
67.2 b 60.03 a 83.61 c |
*Values are expressed as means of triplicate measurements. Superscript letters (a - c) within the same parameter row indicate significant differences among calcination temperatures ( p < 0.05), according to one-way ANOVA followed by Duncan’s multiple range test.

Figure 3 Calcination performance of oyster shells at varying temperatures.
The color difference (ΔE) values of the calcined oyster shell powder were measured to assess the extent of thermal decomposition and phase transformation. As shown in Table 1 , ΔE increased significantly at 1000 °C (83.61), indicating complete decomposition of organic residues and full conversion to CaO, resulting in a brighter and whiter material. At 750 and 900 °C, ΔE values were slightly lower (67.40 and 60.06, respectively), suggesting partial retention of color-contributing impurities or incomplete calcination. The increase in whiteness at higher temperatures is consistent with previous studies using oyster calcined samples at 550 - 900 °C [28].
The whitish color shows the change of structure CaCO 3 into CaO, while the organics were burned off into CO 2 and H 2 O during calcination [42]. The decomposition process was influenced by the temperature applied during calcination process. It was reported that temperatures of ≥ 900 °C was required for complete decomposition, particularly in dense biominerals such as oyster shells. This result was consistent with findings from previous studies on carbonate-based materials, which reported full CaCO₃ conversion to CaO in the range of 850 - 1000 °C [39].
CaO production results
The results of the Ca content analysis showed a significant difference between the sample groups tested at temperatures of 750, 900, and 1000 °C ( Figure 4 ). The ANOVA test yielded an F -value of 28.537 with a significance level ( p < 0.05), indicating a statistically significant difference in calcium content among the groups. The results indicated that increasing the calcination temperature led to a higher calcium content in the CaO samples. Statistical analysis confirmed that the Ca content at 1000 °C was significantly higher compared to lower temperatures ( p < 0.05), demonstrating that higher temperatures promote more complete decomposition of calcium carbonate into calcium oxide. From Duncan’s post-hoc analysis, the Ca content at a temperature of 750 °C had an average of 863,582.55 ppm, at a temperature of 900 °C it increased to 968,815.69 ppm, and at a temperature of 1000 °C it reached 1136659.995 ppm. These results indicate that an increase in treatment temperature correlates with an increase in Ca content in the sample. However, from the Duncan test, there are 2 subsets that show differences in homogeneity, namely the 1 st subset (750 and 900 °C) with a significance of 0.063, and the 2 nd subset (900 and 1000 °C) with a significance of 1.000, indicating that the difference in Ca levels between temperatures of 900 and 1000 °C is more striking than other temperatures.

Figure 4 Value of Ca from oyster shells at 750, 900, and 1000 ° C (Error bars represent (n = 3). Different letters (a) - (c) indicate significant differences ( p < 0.05)).
The results of previous studies found that the Ca composition in oyster shells calcined at 550 - 900 ° C was between 406,910 - 649,100 ppm, which was relatively lower than that found in this study [28]. The significant increase in Ca content from 750 to 1000 °C can be attributed to the efficiency of CaCO₃ decomposition. At 750 °C, the calcination is only partial, where many particles retain carbonate, and thus measured Ca content remains suboptimal. As temperature increases (≥ 900 °C), decomposition proceeds more completely, consistent with findings that temperatures above 750 - 800 °C initiate carbonate breakdown, but ≥ 900 °C is required for full conversion in dense biomatrices such as mollusk shells [27,28]. Consequently, the highest Ca content at 1000 °C reflects an efficient transformation of CaCO₃ to CaO, with minimal residual carbonate. In addition, the differences observed in Ca components among studies can be influenced by the nutrition and age of the oyster, as well as habitat, including temperature, salinity and pH [38,41]. Oyster shells have a high CaCO₃ content, making them a potential source of calcium. CaCO₃ in the shell can be converted into CaO through a calcination process, which has various applications in industry, such as the manufacture of cement, fertilizers, and adsorbent materials [43-45]. The results of testing the mineral content of oyster shells show that the levels of calcium (Ca) contained in the shells can vary depending on environmental factors and species [41]. Based on the Ca content in oyster shells, it is in a relatively high range ( 1,136,659.995 ppm) ( Figure 4 ).
The main component of oyster shells is CaCO₃, which is formed through a biological process when the shell absorbs calcium ions (Ca²⁺) and carbonate (CO₃²⁻) from sea air to form its shell structure [41]. Environmental factors such as pH, air temperature, and the availability of calcium ions greatly affect the mineral composition of the shell [38]. An environment with a low pH (more acidic) can inhibit the formation of CaCO₃, which ultimately affects the calcium levels in the shell.
In addition, variations in mineral content in oyster shells can also be influenced by the age of the shellfish, food availability, and the geographical conditions of its habitat. With a fairly high calcium content, oyster shells have great potential to be used in various industrial applications, especially after going through processing such as calcination to produce more reactive CaO.
The yield of oyster shell powder decreased progressively throughout the processing stages ( Figure 5 ). Initial drying reduced the weight to 90.16%, indicating moisture loss. Subsequent oven heating and grinding further reduced the yield to 88.20% and 81.12%, respectively. Calcination induced significant mass loss due to organic matter decomposition and carbonate release, resulting in yields of 65.49% at 750 °C, and 55.53% and 55.91% at 900 and 1000 °C, respectively. This trend confirms that higher calcination temperatures promote thermal degradation and decarbonation.
The variation reduction in yield observed with the increasing calcination temperature is attributed to the thermal decomposition of CaCO 3 into CaO and the combustion of organic matter into CO 2 and H 2 O [42]. Thus, the lowest yield at 1000 °C reflects the optimum conversion of CaCO 3 into pure CaO, which is desirable for applications requiring high exothermic reactivity and strong antimicrobial performance [23,46-48].
Yield observations were carried out in 2 main stages, namely first in the process of making shell powder before calcination (CaCO₃) and 2 nd in the calcination stage of CaCO₃ powder into CaO. Based on Figure 5 , the yield of oyster shells after the drying process in the sun decreased, ranging from 90.16% of the initial weight. Furthermore, at the oven stage, the yield decreased again by around 88.20%. After going through the process of refining into powder, the final yield produced was in the range of 81.12%.
Compared to other types of shellfish, the highest decrease in yield occurred in oyster shells. This is due to the presence of dirt and other marine organisms attached to the surface of the shell, most of which are lost during the washing and cleaning process [41]. In addition, the texture of oyster shells which is more porous than other types of shellfish can cause increased mass loss during the processing process.

Figure 5 Yield of CaO obtained from oyster shell waste calcined at different temperatures (750, 900, and 1000 °C). Error bars indicate standard deviation (n = 3). Different superscript letters indicate statistically significant differences among the groups ( p < 0.05, Duncan’s test).
At the calcination stage, the yield of CaCO₃ powder converted into CaO depends on the heating temperature. Based on the research results, the calcination temperature of 750 °C produces a higher yield compared to temperatures of 900 and 1000 °C. This is due to the optimal efficiency of air and volatile compound removal at that temperature, while at higher temperatures, further decomposition occurs which causes a decrease in yield [27,28].
Calcination temperatures above 700 °C change CaCO₃ in the shell into CaO in solid form, and release carbon dioxide (CO₂) and air vapor (H₂O) in gas form [42]. This change in chemical structure has a direct effect on the yield of the calcination ash produced. The test results on oyster shells showed that the mass of calcination ash obtained was in accordance with the mass of ash calculated theoretically based on the applicable chemical equation [27]. Choosing the right calcination temperature is a key factor in maintaining optimal yield, especially in the processing of oyster shells to obtain CaO with high efficiency.
Exothermic temperature changes in CaO dissolution from oyster shells
The dissolution of CaO derived from oyster shells exhibited exothermic behavior, as shown in Figure 6 . This temperature increases results from the hydration of CaO to form Ca(OH)₂, releasing heat. The temperature rose sharply post-dissolution, peaked, and then gradually declined due to heat dissipation. The extent of the temperature rise correlates with CaO reactivity, which is influenced by calcination conditions. Higher calcination temperatures yield purer CaO, leading to greater heat release. Additionally, the cooling rate reflects the system’s heat transfer efficiency. These findings highlight the thermal characteristics of oyster shell-derived CaO, relevant for applications in calcium-based materials and Ca(OH)₂ solution formulations.

Figure 6 Exothermic temperature changes in the dissolution of CaO from oyster shells.
An increase in temperature in the environment due to an exothermic reaction occurs when energy is released in the form of heat from a system to the environment. In this study, the exothermic temperature of CaO dissolution from oyster shells that had been calcined at 3 different temperatures (750, 900, and 1000 °C) showed varying patterns of temperature increase ( Figure 6 ).
Based on the observation results, in the 1 st 30 s, the initial exothermic temperature of the 3 calcination temperatures was in the range of 30 - 32 °C. The rate of exothermic temperature increase showed that in the 12 th min, the 1000 °C calcination reached a maximum temperature of 100.4 °C, which means that it had reached the boiling point of water. At a calcination temperature of 900 °C, the maximum temperature achieved was 95.45 °C, with an achievement time of 16 min, while the calcination of 750 °C only reached a maximum temperature of 64.60 °C at 36 min. After each calcination reached the highest temperature, the temperature then decreased gradually to reach 35 - 45 °C in 1 h 16 min.
From these results, it can be concluded that CaO derived from the calcination of oyster shells at a temperature of 1000 °C was able to reach the boiling point of water in the shortest time, which was 12 min. Meanwhile, calcination at a temperature of 900 °C was not able to reach the boiling point of air, although the maximum temperature was quite close. Calcination at a temperature of 750 °C showed a slower rate of temperature increase and was unable to reach the boiling point of air, indicating that the CaO produced at this temperature had lower reactivity than at a higher calcination temperature.
The reactivity of CaO in air is greatly influenced by the particle size and surface area of the CaO powder produced from the calcination process [49]. Calcination at higher temperatures causes the crystal structure of CaO to become more open, making it easier to react with air through the hydration process. This hydration reaction involves Ca²⁺ and O²⁻ ions which react with air to form calcium hydroxide (Ca(OH)₂), which is accompanied by the release of heat as part of the exothermic reaction [50].
In addition, environmental conditions such as air temperature and environmental concentration can also affect the rate of hydration reaction. The finer particle size from high-temperature calcination has a larger surface area, thus accelerating the reaction with air and increasing the exothermic temperature produced [49]. Therefore, the higher the calcination temperature, the faster the hydration reaction takes place, which contributes to an increase in the exothermic temperature in a shorter time.
Thus, oyster shells calcined at a temperature of 1000 °C show the highest reactivity, marked by the achievement of the boiling point of water in the fastest time. Meanwhile, lower calcination temperatures produce CaO with lower reactivity, as indicated by lower exothermic temperatures and longer times to reach maximum temperature.
Enthalpy changes in CaO dissolution from oyster shells
The dissolution of CaO from oyster shells resulted in a significant enthalpy change, as shown in Figure 7 . This exothermic reaction, driven by the hydration of CaO to form Ca(OH)₂, indicates spontaneous heat release. A sharp increase in enthalpy at the onset reflects the rapid progression of the reaction, followed by a gradual decline as the system approaches thermodynamic equilibrium. The magnitude of enthalpy changes correlates with CaO purity and reactivity, both influenced by prior calcination temperature. Higher calcination temperatures enhance CaO reactivity, leading to greater energy release. These enthalpy changes serve as key indicators of the thermochemical properties of the material and are critical for applications in mortar, cement production, and calcium hydroxide-based formulations. Owing to the ability of CaO to release heat during its hydration reaction (−64.9 kJ/mol), it offers a novel approach for rapidly heating products without the use of fire or electricity.

Figure 7 Enthalpy changes in the dissolution of CaO from oyster shells.
In addition to being marked by an increase in ambient temperature, exothermic reactions are also announced by negative enthalpy changes due to the release of energy from the system. Enthalpy is the total energy in a system, which can be positive or negative, depending on the type of reaction that occurs [51]. If the reaction releases heat to the environment, so that the temperature increases (exothermic), then the enthalpy value is negative. Conversely, if the reaction absorbs heat from the environment and causes the temperature to decrease (endothermic), then the enthalpy value is positive.
In the phenomenon of CaO dissolution from oyster shells in water (aquades), there is an exothermic increase in temperature to reach the maximum temperature, then the temperature decreases again to approach the initial temperature. This change indicates a shift in enthalpy from exothermic back to a more stable condition, which can be influenced by the calcination temperature of the shells [27]. The higher the calcination temperature, the greater the remaining energy, so that the negative enthalpy value produced is also greater.
Based on the research results ( Figure 7 ), the largest enthalpy change occurred at 1000 °C calcination, with remaining energy of − 64,915.2 J. Furthermore, at a calcination temperature of 900 °C, the enthalpy change that occurred was − 28,694.4 J, while the lowest enthalpy change occurred at 750 °C calcination, with remaining energy of − 4,233.6 J. When compared with the rate of exothermic temperature increase ( Figure 7 ), it can be seen that the greater the negative enthalpy change, the faster the exothermic temperature reaches the boiling point of water. Calcination at a temperature of 1000 °C was able to reach the boiling point of water (100.4 °C) in just 12 min, while calcination at 900 °C was not able to reach the boiling point of water, with a maximum temperature of 95.45 °C. At a calcination temperature of 750 °C, the remaining energy was much smaller ( − 4,233.6 J), so that the exothermic temperature only reached 64.60 °C and did not reach the boiling point of water.
Based on these results, we concluded that the hydration of CaO from oyster shells calcined at a high temperature (1000 °C) resulted in a more negative enthalpy change. This led to a higher exothermic temperature and a faster reaction time. Conversely, calcination at a lower temperature (750 °C) produced CaO that released less energy, resulting in a lower exothermic temperature and a longer reaction time.
pH value of calcined powder (CaO) from oyster shells
The study revealed that CaO powder obtained from oyster shell calcination exhibited high pH values ( Figure 8 ), reflecting its strong basicity. Upon dissolution, CaO undergoes hydration to form Ca(OH)₂, increasing the pH due to the release of OH⁻ ions. Higher calcination temperatures resulted in higher pH values, indicating increased purity and reactivity of the CaO produced. This trend underscores the role of calcination temperature in influencing the chemical properties of CaO. The elevated pH values are particularly relevant for industrial applications requiring strong alkaline materials, such as wastewater treatment, acid neutralization, and construction material formulation. Therefore, controlling calcination temperature is crucial for optimizing the quality and functionality of CaO derived from oyster shells. Although the final pH values reached 12.5 across all samples, this does not necessarily reflect equal reactivity. The hydration of CaO generates OH⁻ ions until saturation is achieved; beyond this point, pH plateaus regardless of reaction rate. Therefore, pH alone may not sensitively capture kinetic differences in reactivity.

Figure 8 Changes in pH of CaO solutions derived from oyster shell waste calcined at different temperatures (750, 900, and 1000 °C) over a storage period of 0, 4, and 8 h. Error bars represent ± standard deviation (n = 3).
The pH value of CaO powder from oyster shells observed for 8 h showed stability at 12.5 ( Figure 8 ). These results indicate that different calcination temperatures (750, 900, and 1000 °C) did not significantly differ on the pH value of CaO powder. Although measurements were taken at different times (0, 4, and 8 h), the pH still showed strong basic properties without significant changes.
The main reaction in the calcination process is the decomposition of calcium carbonate (CaCO₃) into calcium oxide (CaO) and carbon dioxide (CO₂) [42]. After calcination, CaO is very reactive to air, forming calcium hydroxide (Ca(OH)₂) which has strong basic properties [47]. The formation of Ca(OH)₂ is what causes the CaO solution to have a high pH.
The strong alkaline properties of oyster shell CaO powder have various applications, such as neutralizing acidic waste, improving acidic soil, air treatment, and as an antimicrobial agent [44,47]. Previous research results show that oyster shell waste can increase soil pH and inhibit the growth of gram-positive and gram-negative pathogenic bacteria [1]. CaO powder can increase soil pH from 4.5 to 7.5 and reduce the bioavailability of heavy metals [52].
The mechanism of this pH increase occurs because Ca(OH)₂ is formed from the reaction of CaO with air containing free OH⁻ ions, which effectively neutralizes H⁺ ions in the soil, thereby increasing soil pH [52]. This shows that CaO from oyster shells has great potential in various environmental applications, especially in improving soil and air quality.
FT-IR analysis of oyster shell calcination ash demonstrated changes in functional group characteristics across different calcination temperatures ( Figure 9 , Table 2 ). In this study, interpretation of the FTIR spectra was focused on the key absorption bands above 1500 cm⁻¹, such as hydroxyl and carbonate functional groups, while the fingerprint region (<1500 cm⁻¹) was not discussed in detail due to its complexity and overlapping signals. At 750 °C, distinct absorption peaks corresponding to carbonate groups (CO₃²⁻) were still observed, indicating incomplete decomposition of CaCO₃. At 900 and 1000 °C, the intensity of these bands declined, suggesting progressive conversion of CaCO₃ to CaO. Notably, the spectrum at 1000 °C exhibited stronger CaO-related peaks, confirming higher purity at this temperature. These findings highlight the critical influence of calcination temperature on the chemical composition and transformation efficiency of oyster shell ash. Improved conversion at higher temperatures enhances CaO purity and reactivity, supporting its application in cement production, calcium-based materials, and other industrial processes requiring high-purity alkaline compounds.
The FT-IR spectrum of oyster shell calcination ash was analyzed in the wavelength range of 500 - 4000 cm⁻¹ to identify the characteristics of the functional groups formed ( Figure 9 ). In the spectrum of 500 cm⁻¹, absorption was detected indicating the presence of Ca-O bond vibrations, which are the main characteristics of CaO compounds [18]. In addition, the absorption spectrum at waves of 870, 1126, and 1148 cm⁻¹ indicates the presence of O-C-O bonds, which are stretching vibrations of carbonate ions (CO₃²⁻) [37]. The presence of these carbonate ions is most likely formed due to the reaction between CaO and CO₂ from the air, which produces CaCO₃ [10] .
In the fingerprint area (600 - 1500 cm⁻¹), several spectrum peaks appear indicating Ca-O bonds, further confirming that the main compound in oyster shell calcination ash is CaO [27]. The highest spectrum absorption observed at 3640 cm⁻¹ in pure CaO was also detected in oyster shell calcination ash at around 3636 cm⁻¹. This peak indicates the presence of hydroxyl groups (-OH), which originate from the ability of CaO to absorb air from the air. The hygroscopic nature of the CaO interaction causes air vapor in the atmosphere, forming Ca(OH)₂.
Thus, the analysis of the FT-IR results shows that oyster shell calcination ash at a temperature of 1000 °C is dominated by CaO, with an indication of a small conversion to CaCO₃ due to reaction with CO₂ in the air [10,27,39]. The spectrum appearing around 3600 cm⁻¹ confirms that CaO has a tendency to absorb air, which can lead to the formation of Ca(OH)₂ under humid environmental conditions [10].


Figure 9 FT-IR spectrum of oyster shell calcination ash: (a) 750 °C; (b) 900 °C; (c) 1000 °C, focused on main functional groups above 1500 cm⁻¹.
Table 2 The absorption bands of oyster shells calcined at 750, 900 and 1000 °C.
|
No |
Wavenumber (cm⁻¹) |
Intensity |
Interpretation |
750 °C |
900 °C |
1000 °C |
|
1 |
~3640 - 3400 |
Strong |
O-H stretching (adsorbed water) |
√ |
√ |
√ |
|
2 |
~2920 - 2850 |
Weak |
C-H stretching (organic matter) |
√ |
√ |
√ (2924, 2854) |
|
3 |
~1415 |
Medium |
CO₃²⁻ bending (carbonate group) |
√ |
√ |
X |
|
4 |
~870 |
Medium |
CO₃²⁻ out-of-plane bending |
√ |
√ |
X |
|
5 |
~1125 - 1040 |
Medium |
Si-O or P-O (mineral impurities) |
√ |
√ |
√ (1044, 1129) |
|
6 |
~600 - 500 |
Weak |
Ca-O stretching (indicative of CaO) |
√ |
√ |
√ (603, 529) |
Note: √ means the bands appeared within the spectrum line, while X means the bands disappeared within the spectrum line.
SEM analysis
SEM analysis of oyster shell calcination ash revealed notable changes in surface morphology with increasing calcination temperature ( Figure 10 ), reflecting the thermal decomposition of CaCO₃ into CaO. At 750 °C, the ash exhibited a rough, irregular morphology with poorly developed porosity, indicating incomplete decomposition. At 900 °C, the surface became more porous with signs of finer particle aggregation, suggesting further progression of the reaction. At 1000 °C, a more homogeneous and porous structure with smaller particle sizes was observed, attributed to CO₂ release during calcination. Increased porosity enhances the specific surface area and reactivity of CaO. These findings demonstrate that calcination temperature significantly influences the microstructure of oyster shell ash, with higher temperatures yielding a more porous and uniform morphology. Such characteristics are critical for applications in catalysis, adsorption, and the production of calcium-based materials.
SEM analysis was conducted to observe morphological changes in CaO derived from shellfish waste at various calcination temperatures. At ≤700 °C, CaO particles exhibited irregular shapes and underdeveloped pores, indicating incomplete decomposition. As the temperature increased to 750 - 1000 °C, particles became more homogeneous, with smaller sizes and enhanced porosity. At 900 - 1000 °C, CaO showed a uniform distribution with well-defined morphology and porous surfaces. These structural improvements increase the specific surface area, promoting rapid hydration and greater exothermic heat release. Additionally, the porous structure facilitates better contact with microbial cells, potentially improving antimicrobial activity. Thus, higher calcination temperatures enhance both the thermal and antibacterial properties of CaO. The temperature range of 900 - 1000 °C was found optimal for producing fine, porous CaO particles with improved functional performance [27]. SEM results confirm that calcination temperature plays a critical role in tailoring the morphology of CaO for applications as a heat-generating and antimicrobial agent ( Figure 10 ).

Figure 10 SEM results on oyster shell waste results: (a) 750 °C; (b) 900 °C; (c) 1000 °C.
Inhibitory ability of calcined powder (CaO) from oyster shells against E. coli and S. aureus bacteria
The inhibition test of CaO from oyster shells against E. coli and S. aureus bacteria was carried out on CaO from calcination at a temperature of 1000 °C. The test results showed the formation of a clear zone around the bacterial colony, indicating that CaO powder from oyster shells has the potential as an antimicrobial ( Figures 11 and 12 , and Table 3 ).
The inhibitory power of an antimicrobial substance can be measured based on the diameter of the clear zone formed around the bacterial colony. The wider the clear zone formed, the greater the antibacterial potential of the compound being tested. In the test on E. coli bacteria, the diameter of the inhibition zone formed by CaO powder from oyster shells was 1.17 ± 0.16 mm, which was smaller than antibiotics which had an inhibition zone of 1.75 mm. The results of the analysis showed that the inhibitory power of CaO powder from oyster shells against E. coli was still lower than the standard antibiotic.
On the other hand, in the test against S. aureus bacteria, the inhibitory power of CaO powder from oyster shells had an effectiveness that was almost equivalent to antibiotics, with a clear zone diameter of 1.37 ± 0.19 mm, while antibiotics had a diameter of 1.57 mm. This shows that CaO powder is more effective in inhibiting the growth of gram-positive bacteria such as S. aureus compared to gram-negative bacteria such as E. coli .
The antibacterial effectiveness of CaO powder from oyster shells can be attributed to several main factors. First, CaO has a very basic pH (around 12.5 - 12.7), while bacteria such as E. coli and S. aureus usually grow optimally at a neutral pH (6 - 7.5). When the environment becomes too basic, bacteria experience disruption of cell membranes, ion transport, and enzymatic activity, which can ultimately lead to cell death. Therefore, the primary mechanisms of CaO as antimicrobial agent is influenced by the increase in alkalinity (pH value) of the surrounding bacteria [53].
Second, the antibacterial mechanism of CaO is related to damage to bacterial cell membranes. Bacterial cell membranes consist of phospholipids, proteins, and carbohydrates that play a role in maintaining ion balance, osmotic conditions, and molecular transport. When the environmental pH is too high, OH⁻ ions from Ca(OH)₂ (the result of the reaction of CaO with air) can disrupt the stability of lipids in the cell membrane. As a result, the cell membrane becomes more permeable, causing leakage of important cellular components such as proteins, nucleic acids, and essential ions. This disruption inhibits the metabolic process of bacterial cells, increases osmotic stress, and ultimately causes cell death. In addition, studies from other research results reported that the formation of Ca+ from CaO in the form of slurry will have a negative effect on the surface of the bacterial membrane, causing the cell wall to rupture [47].
Third, oyster shells contain additional compounds such as chitin and chitosan that can strengthen the antibacterial effect. Chitin is a natural polysaccharide that can be found in crustaceans, while chitosan is the result of deacetylation of chitin. Chitosan has a positive charge that can interact with negative processing components in the bacterial cell membrane, causing structural disruption and cell leakage. In addition, chitosan is also able to bind bacterial DNA, thereby inhibiting the replication and growth of microbes. However, further study should be conducted to observe the presence in oyster shell after calcination process.
The difference in the effectiveness of CaO powder in inhibiting E. coli (gram-negative bacteria) and S. aureus (gram-positive bacteria) can also be attributed to the cell wall structure of these 2 bacteria. Gram-negative bacteria such as E. coli have an outer membrane rich in lipopolysaccharides (LPS), which can function as a barrier against antibacterial substances. Meanwhile, gram-positive bacteria such as S. aureus have thicker cell walls but are more easily penetrated by basic compounds, making them more susceptible to the antibacterial effects of CaO.
Thus, CaO powder from oyster shells has great potential as an antibacterial agent, especially against gram-positive bacteria such as S. aureus . The strong basic properties, the ability to damage cell membranes, and the chitin and chitosan content make it potentially used in various applications, such as waste treatment, environmental sterilization, and additives in the treatment of bacterial infections. Many studies have been conducted to determine the capacity of CaO as an antimicrobial agent, which found that most of the sea shells calcined at 1000 °C gave the best antibacterial effect [47,48].
ANOVA analysis confirmed that CaO calcined at 750, 900, and 1000 °C showed no significant difference in antibacterial activity against E. coli and S. aureus . For E. coli , the F-value was 0.704 ( p = 0.562), while for S. aureus , it was 0.653 ( p = 0.581), indicating p -values >0.05. Duncan’s test supported this, with average inhibition zones ranging from 1.2550 - 1.3200 mm for E. coli and 1.2400 - 1.3650 mm for S. aureus ( p = 0.328 and p = 0.334, respectively). In contrast, Ca content increased significantly with calcination temperature. ANOVA revealed an F -value of 59.170 ( p = 0.004), and Duncan’s test showed Ca levels of 1,706,565.1750 (750 °C), 1,969,810.5550 (900 °C), and 2,305,896.6050 (1000 °C), with a significance value of 1.000 across subsets. Despite higher Ca content at elevated temperatures, the antimicrobial effect remained unchanged, suggesting that other factors, such as particle morphology or surface chemistry, may play a more critical role in determining CaO’s antibacterial efficacy [47,48].

Figure 11 Inhibitory ability of oyster shell calcined powder (CaO) against E. coli and S. aureus bacteria.
Figure 12 Inhibitory power of oyster shell microbes: (a) E. coli (left); (b) S. aureus (right).
The antibacterial activity of calcined oyster shell powder (CaO) against E. coli and S. aureu s is presented in Figures 11 and 12 . The study aimed to evaluate the effect of calcination temperature on CaO’s inhibitory efficacy. CaO calcined at 750 °C exhibited the highest inhibition zones for both E. coli (1.355 mm) and S. aureus (1.24 mm). However, a slight reduction in inhibition was observed at 900 and 1000 °C for both bacteria. Despite these variations, ANOVA analysis showed no statistically significant differences across calcination temperatures for E. coli ( F = 0.704; p = 0.562) or S. aureus ( F = 0.653; p = 0.581), further supported by Duncan’s test ( p = 0.328 and 0.334, respectively). The decline in antibacterial activity at higher temperatures is likely attributed to changes in CaO’s surface area and crystalline structure, affecting ion release. Figure 11 illustrates the inhibition zones on agar, with E. coli exhibiting slightly greater sensitivity than S. aureus , potentially due to differences in cell wall structure, gram-negative E. coli having a more permeable outer membrane compared to the thicker peptidoglycan layer in gram-positive S. aureus . These findings suggest that oyster shell-derived CaO possesses antibacterial potential, although its efficacy is influenced by calcination temperature. Further research is warranted to elucidate the underlying antimicrobial mechanisms and to optimize thermal treatment for enhanced antibacterial performance.
Conclusions
This study demonstrated that oyster shell waste can be effectively converted into high-quality calcium oxide (CaO) via calcination, with 1000 °C identified as the optimal temperature for complete CaCO₃ decomposition. The resulting CaO exhibited high basicity (pH ~12.5), thermal reactivity, and antimicrobial potential. SEM analysis revealed that higher calcination temperatures produced finer, more porous particles, enhancing surface area and reactivity. XRD and FTIR confirmed high crystallinity and complete transformation to CaO. TGA supported CO₂ release during thermal decomposition, while UV-Vis analysis indicated potential photocatalytic interaction with microorganisms.
CaO displayed exothermic heat release upon hydration, indicating its suitability as a self-heating material. Antibacterial tests showed more pronounced inhibition against S. aureus than E. coli , attributed to CaO’s strong alkalinity and possible synergistic effects from residual chitin/chitosan. Despite increased Ca content at higher temperatures, no significant differences in inhibition zones were observed, suggesting morphology plays a larger role in antimicrobial activity.
These findings support the valorization of oyster shell waste as a sustainable, multifunctional material for use in environmental remediation, agriculture, packaging, and heat-generating applications—aligning with circular economy principles.
Acknowledgements
Thank you to the Ministry of Marine Affairs and Fisheries, Indonesia for their generous support.
Declaration of Generative AI in Scientific Writing
The authors acknowledge the use of generative AI tools (e.g., QuillBot and ChatGPT by OpenAI) in the preparation of this manuscript, specifically for language editing and grammar correction. No content generation or data interpretation was performed by AI. The authors take full responsibility for the content and conclusions of this work.
CRediT Author Statement
I Gusti Ayu Budiadnyani: Conceptualization, Methodology, Software, Validation, Formal analysis, Investigation, Resources, Data Curation, Writing - Original Draft, Writing - Review & Editing, Visualization, Supervision, Project administration, Funding acquisition. Pinky Natalia Samanta: Methodology, Software, Validation, Formal analysis, Investigation, Resources, Data Curation, Project administration. Fenny Crista Anastasia Panjaitan: Methodology, Software, Validation, Formal analysis, Investigation, Resources, Data Curation, Project administration. Anis Khairunnisa: Methodology, Software, Validation, Formal analysis, Investigation, Resources, Data Curation, Writing - Original Draft, Writing - Review & Editing, Visualization, Supervision. I Made Aditya Nugraha: Methodology, Software, Validation, Writing - Original Draft, Writing - Review & Editing, Visualization.
References
[1] S Ulagesan, S Krishnan, TJ Nam and YH Choi. A review of bioactive compounds in oyster shell and tissues. Frontiers in Bioengineering and Biotechnology 2022; 10 , 913839.
[2] C Xu, R Liu and L Chen. Removal of phosphorus from domestic sewage in rural areas using oyster shell-modified agricultural waste-rice husk biochar. Processes 2023; 11(9) , 2577.
[3] S Tongwanichniyom, T Pattamapitoon, N Sangvichien and S Phornphisutthimas. Production of calcium oxide from waste oyster shells for a value-added application of antibacteria. Ecology, Environment and Conservation 2021; 27(2) , 539-547.
[4] R Botta, F Asche, JS Borsum and EV Camp. A review of global oyster aquaculture production and consumption. Marine Policy 2020; 117 , 103952.
[5] R Shobana, S Vijayalakshmi, B Deepanraj and J Ranjitha. Biodiesel production from Capparis spinosa L seed oil using calcium oxide as a heterogeneous catalyst derived from oyster shell. Materials Today: Proceedings 2023; 80(3) , 3216-3220.
[6] L Wang, Y Liu, X Peng, Y Sun, X Liu, H Liu, Q Lin, H Sun, B Yang and X Li. Preparation and characterization of CaO/ZnO core-shell structured nanoparticles. Chemical Research in Chinese Universities 2020; 36 , 970-975.
[7] S Kumar, V Sharma, JK Pradhan, SK Sharma, P Singh and JK Sharma. Structural, optical and antibacterial response of CaO nanoparticles synthesized via direct precipitation technique. Nano Biomedicine and Engineering 2021; 13(2) , 172-178.
[8] G Marquis, B Ramasamy, S Banwarilal and AP Munusamy. Evaluation of antibacterial activity of plant mediated CaO nanoparticles using Cissus quadrangularis extract. Journal of Photochemistry and Photobiology B 2016; 155 , 28-33.
[9] AF Rusdaryanti, U Amalia and S Suharto. Antibacterial activity of CaO from blood cockle shells ( Anadara granosa ) calcination against Escherichia coli . Biodiversitas 2020; 21(6) , 2827-2831.
[10] W Srichanachaichok and D Pissuwan. Micro/nano structural investigation and characterization of mussel shell waste in Thailand as a feasible bioresource of CaO. Materials 2023; 16(2) , 805.
[11] K Zheng, F Bider, M Monavari, Z Xu, C Janko, C Alexiou, AM Beltrán and AR Boccaccini. Sol-gel derived B 2 O 3 -CaO borate bioactive glasses with hemostatic, antibacterial and pro-angiogenic activities. Regenerative Biomaterials 2024; 11 , rbad105.
[12] GN Mediarman, Sumardianto, PH Riyadi, L Rianingsih and L Purnamayati. Potentials of CaO powder result of calcination from green shells ( Perna viridis ), scallops ( Placuna placenta ), and blood clams ( Anadara granosa ) as antibacterial agent. In : Proceedings of the 2 nd International Conference on Fisheries and Marine, Ternate, Indonesia. 2021.
[13] X Liang, R Dai, S Chang, Y Wei and B Zhang. Antibacterial mechanism of biogenic calcium oxide and antibacterial activity of calcium oxide/polypropylene composites. Colloids and Surfaces A: Physicochemical and Engineering Aspects 2022; 650 , 129446.
[14] X Meng, Z Xu, C Wang, J Patitz, AR Boccaccini, A Burkovski and K Zheng. Surface engineering of mesoporous bioactive glass nanoparticles with bacteriophages for enhanced antibacterial activity. Colloids and Surfaces B: Biointerfaces 2024; 234 , 113714.
[15] SH Chang, YJ Chen, HJ Tseng, HI Hsiao, HJ Chai, KC Shang, CL Pan and GJ Tsai. Antibacterial activity of chitosan-polylactate fabricated plastic film and its application on the preservation of fish fillet. Polymers 2021; 13(5) , 696.
[16] J Widakdo, TM Chen, MC Lin, JH Wu, TL Lin, PJ Yu, WS Hung and KR Lee. Evaluation of the antibacterial activity of eco-friendly hybrid composites on the base of oyster shell powder modified by metal ions and LLDPE. Polymers 2022; 14 , 3001.
[17] M Manoj, O Manaf, KM Ismayil and A Sujith. Composites based on poly(ethylene-co-vinyl acetate) and silver-calcined scallop shell powder: Mechanical, thermal, photocatalytic, and antibacterial properties. Journal of Elastomers and Plastics 2021; 53(7) , 902-921.
[18] YC Chen, CL Lin, CT Li and DF Hwang. Structural transformation of oyster, hard clam, and sea urchin shells after calcination and their antibacterial activity against foodborne microorganisms. Fisheries Science 2015; 81 , 787-794.
[19] SS Karkal, DR Rathod, AS Jamadar, PV Suresh, HNP Kumar and TG Kudre. Fenneropeanus indicus shrimp shell and fishmeal oil: A novel feedstock for biodiesel production and bio derived heterogeneous catalyst development. Catalysis Letters 2024; 154 , 1521-1536.
[20] M Mahidin, A Gani, MR Hani, M Syukur, H Hamdani, K Khairil, S Rizal, A Hadi and TMI Mahlia. Use of green mussel shell as a desulfurizer in the blending of low rank coal-biomass briquette combustion. Makara Journal of Technology 2016; 20 , 97-102.
[21] SFS Mohamad, S Mohamad and Z Jemaat. Study of calcinations condition on decomposition of calcium carbonate in waste cockle shell to calcium oxide using thermal gravimetric analysis. ARPN Journal of Engineering and Applied Sciences 2016; 11(16) , 9917-9921.
[22] YS Liu, KX Tang, YT Liao, RR Huang, Y Zhu, Z Chen, Y Chen and L Lin. Calcined and hydrated shell powder with layered porous structures for food sterilization and pesticide residue removal. In : Proceedings of the Chinese Materials Conference 2022-2023, Shenzhen, China. 2023.
[23] WC Lu, CS Chiu, CW Hsieh, YJ Chan, ZC Liang, CCR Wang, AT Mulio, DHT Le and PH Li. Calcined oyster shell powder as a natural preservative for maintaining quality of white shrimp ( Litopenaeus vannamei ). Biology 2022; 11 , 11020334.
[24] Y Hata, S Hiruma, H Miyazaki and S Nakamura. Sequential approach for water purification using seashell-derived calcium oxide through disinfection and flocculation with polyphosphate for chemical pollutant removal. ACS Omega 2023; 9(11) , 12635-12642.
[25] S Dampang, E Purwanti, F Destyorini, SBKB Kurniawan, SRS Abdullah and MF Imron. Analysis of optimum temperature and calcination time in the production of CaO using seashells waste as CaCO 3 source. Journal of Ecological Engineering 2021; 22(5) , 221-228.
[26] A Bucur, R Banica, MC Pascariu, M Poienar, C Mosoarca, R Bucur, A Negreaa and I Hulka. Eco-valorification of marine shells by hydrothermal conversion in alkaline media. Digest Journal of Nanomaterials and Biostructures 2022; 17(1) , 153-160.
[27] SC Wu, HC Hsu, SK Hsu, CP Tseng and WF Ho. Effects of calcination on synthesis of hydroxyapatite derived from oyster shell powders. Journal of the Australian Ceramic Society 2019; 55 , 1051-1058.
[28] N Suwannasingha, A Kantavong, S Tunkijjanukij, C Aenglong, HB Liu and W Klaypradit. Effect of calcination temperature on structure and characteristics of calcium oxide powder derived from marine shell waste. Journal of Saudi Chemical Society 2022; 26 , 101441.
[29] S Suprihadi, A Thaib, N Nurhayati and L Handayani. The potential of fishery waste as an alternative source of natural calcium: A review. Acta Aquatica: Aquatic Sciences Journal 2023; 10 , 163-171.
[30] Q Zhou, B Wu, K Chen, L Ji and Y Wu. Study on thermal decomposition kinetic mechanism and calcination process of phosphorus tailings. Inorganic Chemicals Industry 2023. https://doi.org/10.19964/j.issn.1006-4990.2022-0295
[31] SAC Hockaday, F Dinter and QG Reynolds. The thermal decomposition kinetics of carbonaceous and ferruginous manganese ores in atmospheric conditions. Journal of the Southern African Institute of Mining and Metallurgy 2023; 123(8 ), 391-398.
[32] Q Yin, H Song, M Xu, H Yan, Y Zhao and X Duan. Thermal decomposition of carbonates coupled with dry reforming of methane to synthesize high-value products: A perspective ( in Chinese ). Acta Physica Sinica 2023; 39(3) , 2210026.
[33] S Seesanong, Y Wongchompoo, B Boonchom, C Sronsri, N Laohavisuti, K Chaiseeda and W Boonwee. Economical and environmentally friendly track of biowaste recycling of scallop shells to calcium lactate. ACS Omega 2022; 7(17) , 14756-14764.
[34] M Olszak-Humienik and M Jablonski. Thermal behavior of natural dolomite. Journal of Thermal Analysis and Calorimetry 2015; 119 , 2239-2248.
[35] J Zheng, J Huang, L Tao, Z Li and Q Wang. A multifaceted kinetic model for the thermal decomposition of calcium carbonate. Crystals 2020; 10(9) , 849.
[36] R Akasaka, A Osawa, R Wada, J Sawai and Y Nakagawa. Antimicrobial activity and transparency of polyvinyl butyral paint containing heated scallop-shell powder. Coatings 2023; 13(2) , 364.
[37] N Tangboriboon, R Kunanuruksapong and A Sirivat. Preparation and properties of calcium oxide from eggshells via calcination . Materials Science-Poland 2012; 30 , 313-322.
[38] MS Sankar, P Dash, YH Lu, X Hu, AE Mercer, S Wickramarathna, WT Beshah, SL Sanders, Z Arslan, J Dyer and RJ Moorhead. Seasonal changes of trace elements, nutrients, dissolved organic matter, and coastal acidification over the largest oyster reef in the Western Mississippi Sound, USA. Environmental Monitoring and Assessment 2023; 195(1) , 175.
[39] S Seesanong, C Seangarun, B Boonchom, N Laohavisuti, W Boonmee, S Thompho and P Rungrojchaipon. Low-cost and eco-friendly calcium oxide prepared via thermal decompositions of calcium carbonate and calcium acetate precursors derived from waste oyster shells. Materials 2024; 17 , 3875.
[40] S Seesanong, C Laosinwattana, K Chaiseeda and B Boonchom. A simple and rapid transformation of golden apple snail ( Pomacea canaliculata ) shells to calcium carbonate, monocalcium and tricalcium phosphates . Asian Journal of Chemistry 2019; 31(11) , 2522-2526.
[41] PSCD Silva, WDM Farias, MRBP Gomez, JK Torrecilha, FR Rocha, MA Scapin, RHL Garcia, LRLD Simone and VSD Amaral. Oyster shell element composition as a proxy for environmental studies. Journal of South American Earth Sciences 2024; 134 , 104749.
[42] M Sari and Y Yusuf. Synthesis and characterization of hydroxyapatite based on green mussel shells ( Perna viridis ) with calcination temperature variation using the precipitation method. International Journal of Nanoelectronics and Materials 2018; 11(3) , 357-370.
[43] JH Seo, SM Park, BJ Yang and JG Jang. Calcined oyster shell powder as an expansive additive in cement mortar. Materials 2019; 12(8) , 1322.
[44] X Yang, K Liu, Y Wen, Y Huang and C Zheng. Application of natural and calcined oyster shell powders to improve latosol and manage nitrogen leaching. International Journal of Environmental Research and Public Health 2023; 20(5) , 3919.
[45] MH Azarian and W Sutapun. Biogenic calcium carbonate derived from waste shells for advanced material applications: A review. Frontiers in Materials 2022; 9 , 1024977.
[46] B Janković, N Manić, M Jović and I Smičiklas. Kinetic and thermodynamic analysis of thermo-oxidative degradation of seashell powders with different particle size fractions: Compensation effect and iso-equilibrium phenomena. Journal of Thermal Analysis and Calorimetry 2022; 147 , 2305-2334.
[47] E Brakemi, K Michael, SP Tan and H Helen. Antimicrobial activity of natural mollusc shells: A review. Process Biochemistry 2024; 137 , 122-133.
[48] J Zhang, B Zheng, C Zhang, L Xie and C Fang. Calcined waste shells as a promising, eco-friendly adsorbent, antimicrobial, food preservative, and food packaging material: A mini review. Journal of Food Process Engineering 2023; 46(12) , e14477.
[49] S Lin, M Harada, Y Suzuki and H Hatano. CaO hydration rate at high temperature ( ∼ 1023 K). Energy and Fuels 2006; 20(3) , 903-908.
[50] Y Fang, J Zhao, C Zhang and Y Li. Exothermic performance of the calcined limestone determined by exothermic temperature under fluidization during CaCO 3 /CaO energy storage cycles. Journal of Thermal Science 2023; 32 , 1784-1796.
[51] U Ryde. A fundamental view of enthalpy-entropy compensation. MedChemComm 2014; 5 , 1324-1336.
[52] S Kuo, MS Lai and CW Lin. Influence of solution acidity and CaCl 2 concentration on the removal of heavy metals from metal-contaminated rice soils. Environmental Pollution 2006; 144(3) , 918-925.
[53] K Sadeghi, K Park and J Seo. Oyster shell disposal: Potential as a novel ecofriendly antimicrobial agent for packaging: A mini review. Korean Journal of Packaging Science and Technology 2019; 25(2) , 57-62.